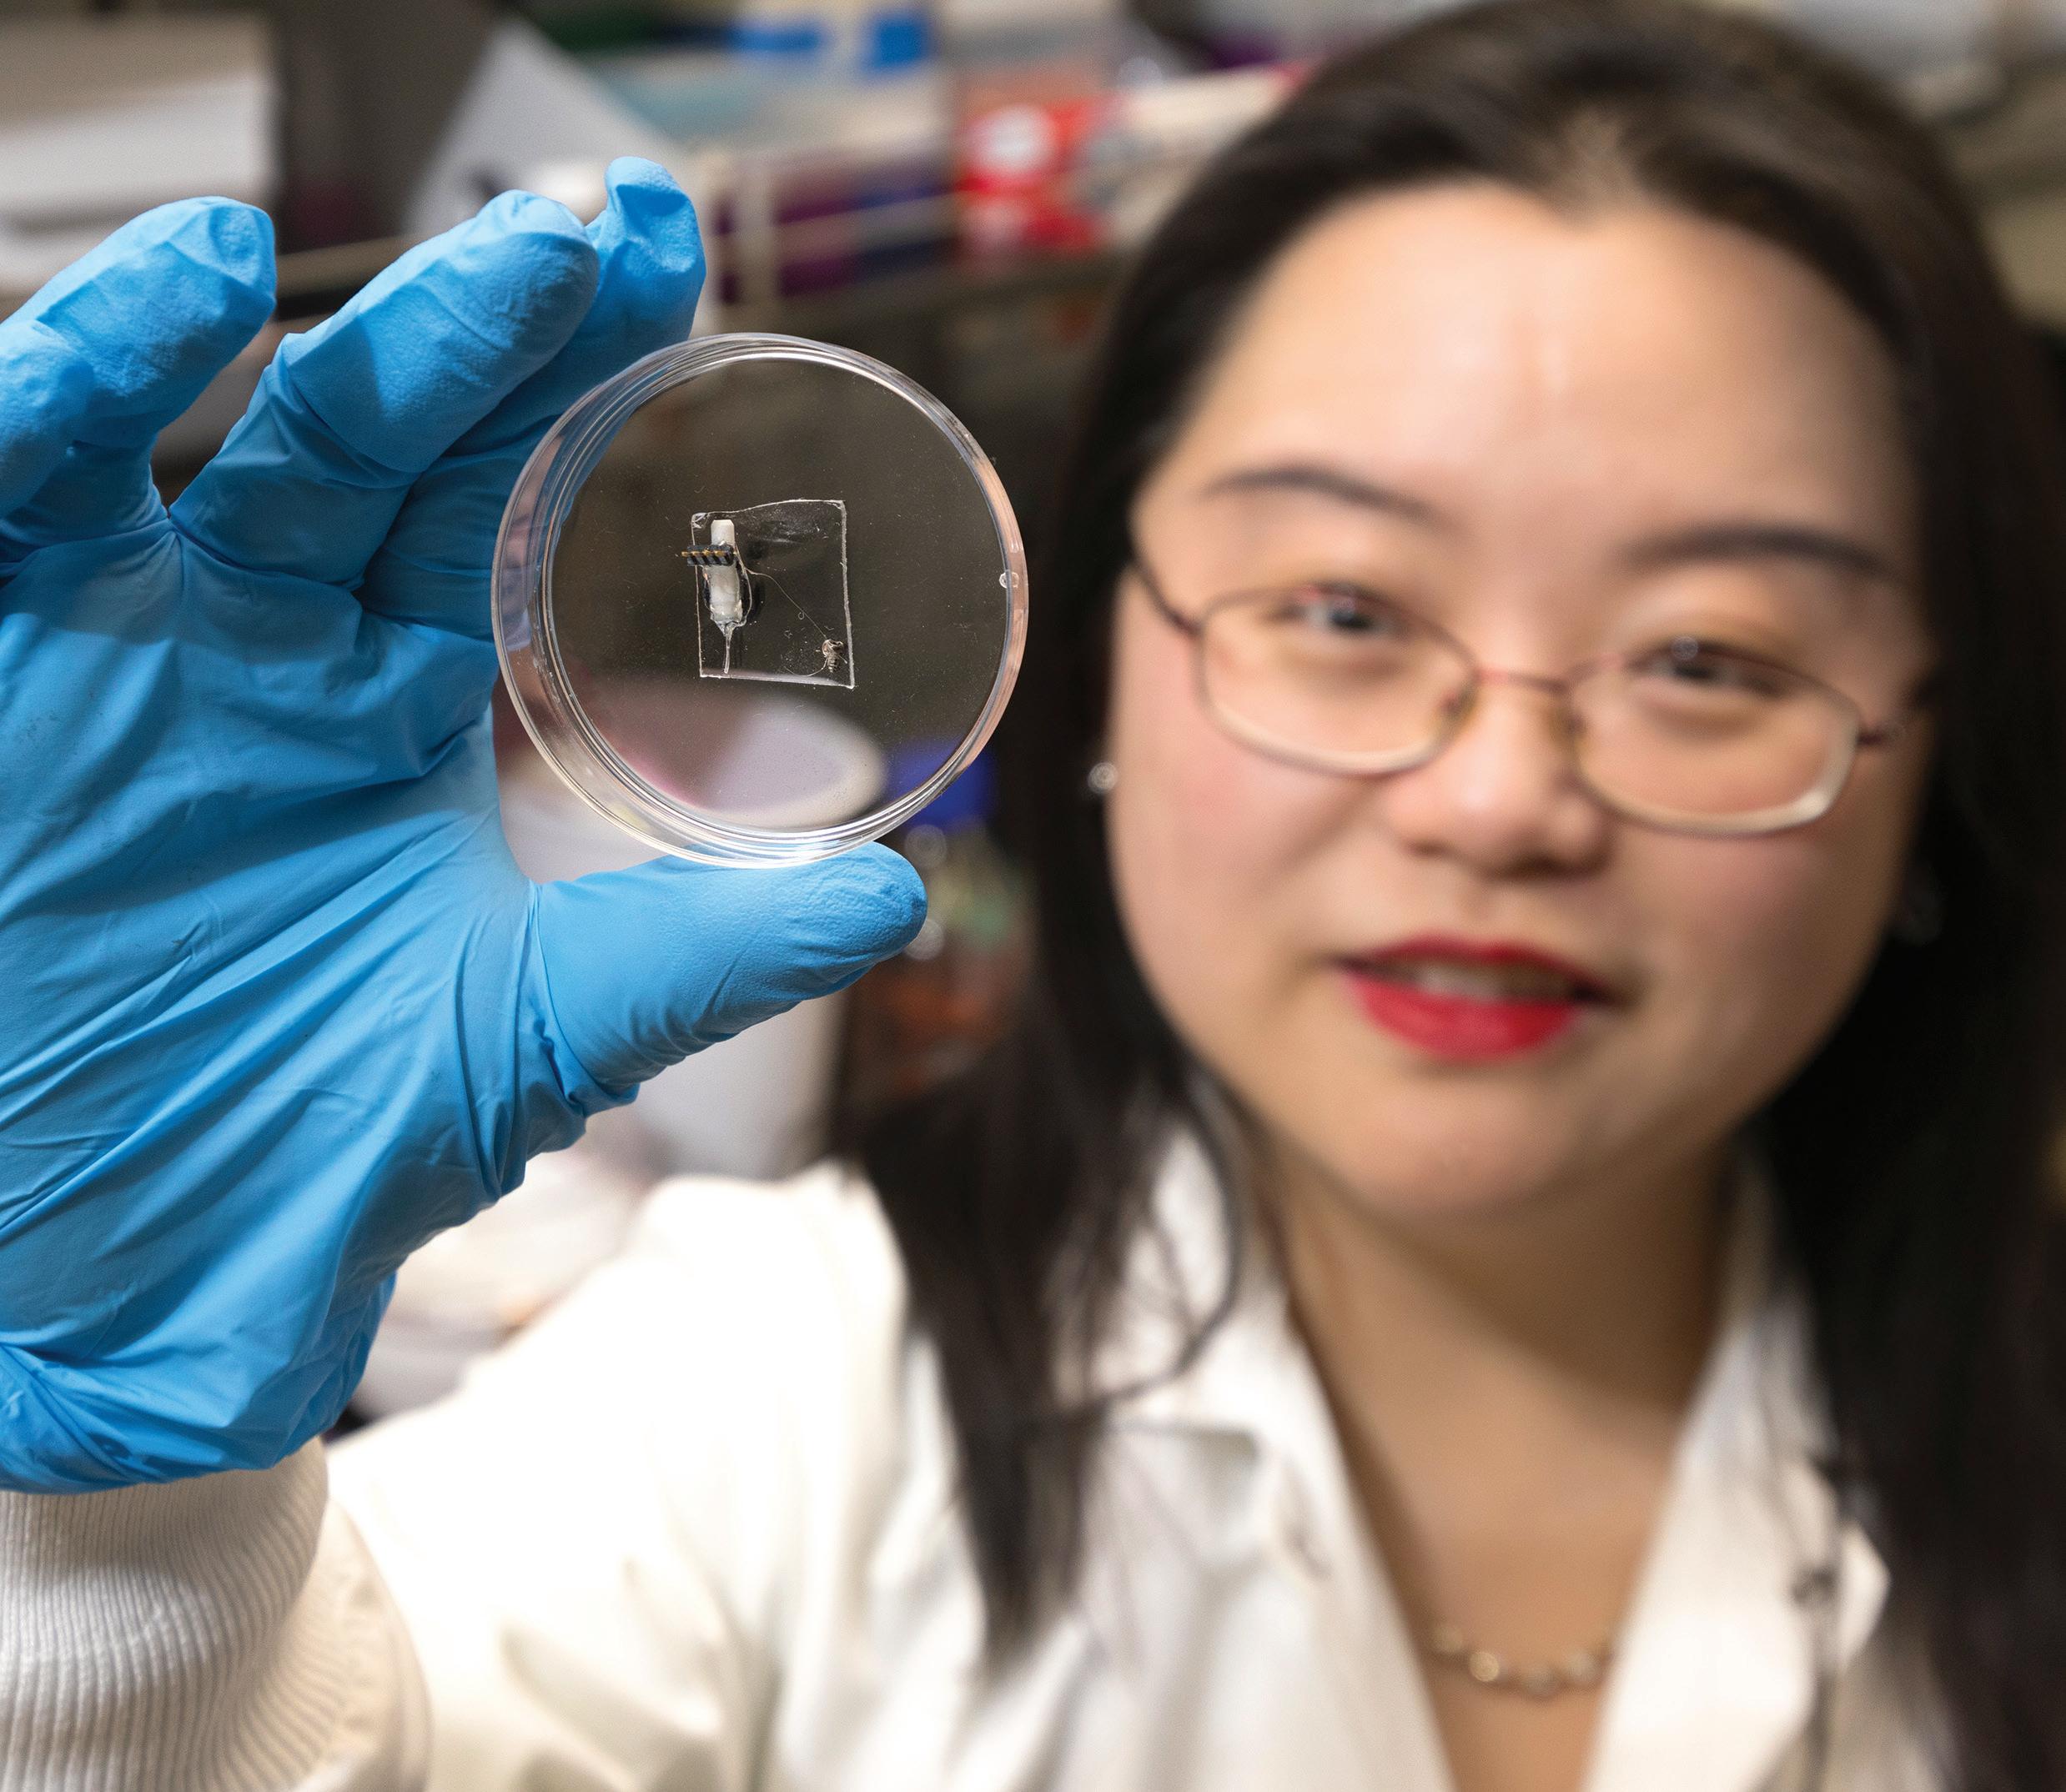

University
![]()

University
The results are in
We raised a record-breaking
$261,643,369
That’s more than $10 million over our goal and more than 2.5 times our last campaign!
35,023 donors gave
Every donor, every gift, all of your help made a difference.
$261,643,369 Thank you!
When we started this campaign seven years ago, we envisioned achieving something big for Binghamton. You joined in and gave generously to EXCELERATE the people, places and programs that make our campus thrive.
In the end, we’re a better University, thanks to you.
With your support, this small, liberal arts college founded in 1946 has transformed into a Nobel Prize-winning, top R1 research institution that consistently ranks high in value, academics, alumni success and global impact. Binghamton has done in mere decades what it has taken others centuries to accomplish — even amid worldwide challenges of the COVID-19 pandemic.
You fueled the momentum to:
• Open doors for the brightest minds from across the globe.
• Boost Binghamton’s competitiveness in the higher education landscape.
• Elevate the University’s reputation as a beacon of excellence.

As we celebrate our EXCELERATE success and look ahead to the start of Binghamton’s next era, you are helping us


Never in Binghamton’s history have we excelled so far, so fast.
July 1, 2017 EXCELERATE campaign for Binghamton begins, providing essential support to create the university of tomorrow, today.
August 2018 School of Pharmacy and Pharmaceutical Sciences building on the Health Sciences Campus in Johnson City, N.Y., officially opens to students, featuring technology not available in many pharmacy schools, pathbreaking research labs, a cutting-edge simulation lab and more.
October 2019 M. Stanley Whittingham, distinguished professor of chemistry and of materials science, receives 2019 Nobel Prize in Chemistry for pioneering research leading to the development of the lithium-ion battery.

February 2020 $60 million anonymous gift announced to fully fund the development of a new Baseball Stadium Complex. It’s the largest single gift ever to support Binghamton. The baseball team plays its first game there in March 2022.
The Dr. G. Clifford & Florence B. Decker Foundation — one of the University’s most generous supporters — helped make the vision for the Health Sciences Campus and other places of innovation and knowledge creation at Binghamton a reality by funding ultramodern programs, instrumentation and infrastructure.
Spring 2021 Decker College of Nursing and Health Sciences officially opens on the Health Sciences Campus, consisting of the Decker School of Nursing (founded in 1969), as well as the School of Rehabilitation Sciences and the School of Applied Health Sciences (both established in 2019). Decker College is also home to the Innovative Simulation and Practice Center, helping to transform teaching, learning and health sciences education.

Fall 2021 Innovation Lab opens in Glenn G. Bartle Library, combining academics, experiential learning, networking and mentorship; fostering interdisciplinary skills; and helping students create comprehensive solutions for the economy’s greatest challenges.

Fall 2021 Nationally recognized Transformational Leaders Program launches to promote successful professional trajectories for students who have overcome adversity or face barriers to being in higher education. Participants receive personal, academic and career development opportunities tailored to individual needs.
Fall 2021 Watson College Scholars Program launches to support underrepresented minoritized (URM), female and economically-disadvantaged students who are strong candidates for graduate study and professional careers in engineering or computer science.

February 2022 The Motion Analysis Research Lab opens in the West Gym, a high-tech facility for faculty clinical research, immersive and dynamic student-learning experiences, and communityoutreach initiatives.
April 9, 2022 Public launch of the EXCELERATE campaign, with a fundraising goal of $220 million.
September 2022 Binghamton University Speech, Language and Hearing Clinic opens in the Binghamton University JC Center on Gannett Drive in Johnson City, N.Y., to deliver speech and language therapy services to the community and provide clinical training opportunities for students. The center is also home to a Speech Language Analysis Laboratory.
January 2023 Anonymous gift announced to provide $25 million in endowed, merit-based Binghamton Achievement Scholarships to attract the best undergraduate students to Binghamton, and $12.5 million to endow Graduate Student
of the Arts scholarships that support students pursuing a Master of Fine Arts. Recipients start receiving support for the fall 2023 semester.
Spring 2023 Anatomy and Physiology Laboratory opens in Academic Building B. Equipped with high-fidelity simulation and other innovative equipment to support graduate physical therapy and undergraduate nursing and health science anatomy and physiology education, making it a unique teaching facility in the Northeast.

Summer 2023 Christopher Robbins begins duties as the founding director of the new School of the Arts, which unites five award-winning programs: art and design, art history, cinema, music and theatre. Students gain opportunities through collaborations with the Binghamton University Art Museum, Anderson Center for the Performing Arts, and the Creative Writing program.
More donors than ever before gave gifts of over $1 million to advance Binghamton!
The Binghamton University Foundation’s endowment more than doubled during the campaign, from $111 million to $245 million, meaning your impact on the University’s future and our campus grew significantly.
$179.3 million in Foundation support was spent across campus over the course of the campaign.
July 2023 Ford Family Wellness Center for Seniors opens on Jennison Avenue in Johnson City, N.Y., diagonally across from the Decker College of Nursing and Health Sciences.
August 2023 The S. H. Ho Foundation Ltd. makes a $5.6 million gift to advance faculty research at Binghamton University. It’s the largest single gift Binghamton has ever received from an organization.
Oct. 29, 2023 The Campaign Committee announces a $250 million Super Goal.


April 17-18, 2024 The Binghamton Fund EXCELERATOR Challenge launches. More than 2,000 donors participated — more than doubling our goal — and we raised $760,305 for the Binghamton Fund.
June 30, 2024 EXCELERATE campaign ends raising $261.6 million from 35,023 donors!
Sept. 27-29, 2024 EXCELEBRATION during Homecoming at Binghamton, when campaign donors and volunteers, students, faculty and friends reveled in Bing pride, the success of the campaign and saw the powerful impact of their support across campus. A dedication of the Charlene and Roger Kramer Welcome Center was also held.


$147 million to ensure an exceptional education
$67 million to make the exceptional accessible
$31 million to spark discovery for a changing world
$16 million to speed success through the Binghamton Fund
Exceptional education Access Discovery
Binghamton Fund
Alumni (17,305)
Parents (7,888)
Friends (7,493)
Corporations, foundations, organizations (1,107)
Faculty/staff (824)
Students (335)
Donor-advised funds (71)
Total: 35,023
Based on current and primary constituency. For example, some made campaign gifts when they were students but have since graduated and are listed here as alumni.
Roughly 18,500 — or over half of all EXCELERATE supporters — were first-time donors!

All gifts make a difference
Cash $240,794,067
Gifts in kind $7,615,643
Deferred $9,253,927
Non-governmental grants $3,979,732
Total $261,643,369
More than double its value in FY 2017-18! $245,045,322
FY 2017-18
$112,705,692
FY 2018-19 $119,421,943
FY 2019-20 $117,839,536
FY 2020-21 $148,121,733
FY 2021-22 $136,992,973
FY 2022-23 $182,735,963
FY 2023-24 $245,045,322
FY 2017-18
$12,809,491
FY 2018-19
$13,358,689
FY 2019-20
$14,951,156
FY 2020-21 $18,216,091
FY 2021-22 $23,083,934
FY 2022-23 $74,996,197
FY 2023-24 $21,897,846
Your impact in fiscal year 2023-24
Total dollars raised $18,792,012
Total donors
9,809 (up 3% from the previous year)


Your impact on Binghamton’s future and our campus:
$21,897,846 in donor-funded expenditures
Our endowment is growing for generations to come — valued at $245,045,322 as of June 30, 2024 (up 34% from $182,735,963 the previous year)



$147 million
The EXCELERATE campaign saw the launch of the Innovation Lab, where creativity and new ideas ignite.
The lab and Innovation Scholars program attract the next generation of visionaries and doers. Creatives, engineers, scientists and business specialists meet up in the common space at the core of the lab — the Nesvold Nexus — and connect with visionary thought leaders from Binghamton’s academia and industry. The result? Novel solutions to complex problems generated from the diverse perspectives and knowledge from different disciplines.
Jacob Goodman ’21, MS ’23, was part of the first cohort of sophomore students recruited as Innovation Scholars for the three-year program, which was launched in 2018. Amid the COVID-19 pandemic, he built a prototype of a working ventilator using parts he bought at Walmart.
Goodman was “one of our most impressive students, just a real gogetter,” said James Pitarresi, vice provost for online and innovation education. “This is getting back to American ingenuity — the spirit of ‘let’s figure out how to do this.’”




The EXCELERATE campaign paved the way for the largest gift ever to the Binghamton Fund for the College of Community and Public Affairs, to enhance the Binghamton University Community Schools (BUCS) program. Through BUCS, the University, school districts and community agencies partner to leverage resources and reduce barriers to learning for students from elementary school to high school.
“They love and are committed to making the world a better place through education at Binghamton University,” CCPA Dean Laura Bronstein said about the donors.
“ The program has opened more doors for me than I could have imagined.
I’ve made numerous connections with those in career services, the Dean’s Suite, my peers, and I was able to receive an internship. I just hope to inspire young women to follow their passions when it comes to the business world, because it can be very hard and intimidating always seeing men in such positions. I hope to be able to one day be that doorway or window of opportunity for someone in the position I once was.”
— Transformational Leaders Program participant and aspiring accountant Yuliah Johnson ’25

“ Overall, my time has been truly unforgettable
and made me feel like I’m using what I’ve done in Binghamton to make a positive difference in people’s lives. Working with refugees in this placement has solidified my interest in learning more about the conflicts that have manufactured migration.”
— Maya Tierney ’22 about her Binghamton Fund-supported internship with the Refugee Rights Hub, based in the Helena Kennedy Centre for International Justice at Sheffield Hallam University in England. As a Binghamton alumna, she’s continued to follow her passion for justice as a paralegal helping survivors of domestic violence. She’s staying connected to Binghamton as a member of the BOLD Leadership Council.


As part of the EXCELERATE campaign, you enabled students to conduct pioneering research as soon as their first year on campus through programs such as the Source Project and First-year Research Immersion.
The Source Project, supported by the Binghamton Fund, is one of the few programs in the nation that offer first-year students research experiences in the humanities and social sciences. Students admitted into this undergraduate honors program choose from a variety of research “streams.” They work one-onone with faculty and students to learn how to evaluate information and draw evidence-based conclusions.


Kate Langsdorf, a junior majoring in Asian studies and philosophy, politics and law (PPL), enrolled in the Thinking Through Painting stream. Her analysis of a painting created by a Japanese immigrant is now part of the Binghamton University Art Museum’s permanent collection. Langsdorf was also chosen to speak about her research on the transmission of Buddhism’s effect on women in Korea at a SUNY Oneonta philosophy conference. Her passion for Asia made winning the Critical Language Scholarship Spark (CLS Spark) — a prestigious national award through the U.S. State Department — especially rewarding.
“I didn’t know research in the humanities could even be an option for me my first semester. The Source Project really showed me how much I love researching,” she said.
“I’m going to be using the scholarship to begin my study of Mandarin, which will be instrumental as I move on to graduate school and begin to work with Korean history, since many older records are in Classical Chinese and Mandarin.”



Aeryn Zahn, an environmental sciences major, made an important discovery as part of her Source Project research: a book once owned by Sir Hans Sloane, whose collection is the foundation of the British Museum. It was a discovery that rocked the Source Project’s Bookmaking stream and the University Libraries’ Special Collections.
“He is historically thought of as one of the great founding collectors of one of the most extensive collections of books in the world,” said Associate Professor of English Bridget Whearty. “A huge part of the significance of Aeryn’s find is that it really shows what well supported, determined first-year students are capable of.”
Zahn doesn’t know yet how Binghamton obtained the book, but she wants to continue tracing its past.
“And then, hopefully, I can write something that gets published,” she said.
By senior year, Arthur O’Sullivan ’24, a First-year Research Immersion student, won a Binghamton Fund-supported Undergraduate Research Award for a project inspired by his undergraduate studies in biology and in classical civilization. His research was an interdisciplinary effort to build on others’ previous findings about the antibiotic properties of narcissus and honey and explore modern approaches to ancient medicinal remedies. Now, he’s working on earning his Binghamton master’s degree in biology and expanding his research experience in new areas of microbiology. He said the award boosted his confidence as a researcher and pride in his work.
“Receiving the award made my day.”

“ Thanks to this gift, the next few years at I-GMAP will be a very exciting time.”
The EXCELERATE campaign saw generous support to grow the groundbreaking Institute for Genocide and Mass Atrocity Prevention (I-GMAP) and its impact on undergraduate and graduate education, and the world. Significant investments in faculty, post-doctoral fellows, research and more, are bringing national and global attention to the University as a leading actor in the international community of atrocity prevention scholars and practitioners.
“The Scheidt Family Foundation’s first gift established I-GMAP. Its second, larger gift allowed us to grow during some very difficult times, including the COVID pandemic and the death of our co-founder,” said Max Pensky, philosophy professor and I-GMAP co-director. “This newest and largest gift from the Foundation is transformational. With this generous support, we will dramatically scale up our existing programs and launch a range of new initiatives.”



Through EXCELERATE, you’re advancing the newest school on campus: the School of the Arts within Harpur College of Arts and Sciences. The school held its inaugural Student Showcase with support from the Binghamton Fund.

“The showcase provides an opportunity to shine a spotlight on these interdisciplinary connections, as well as the inspired work and performance of Binghamton students,” said the school’s founding director, Christopher Robbins. “Our School of the Arts is built from award-winning programs within an acclaimed Research-1 University. The work that comes out of this combination is exciting and groundbreaking, and this is a chance to see it all coming together!”

The EXCELERATE campaign generated significant support for the University Libraries, including a planned gift that will provide for the maintenance and enhancement of the on-campus collection of a renowned writer’s poetry, personal memorabilia and more, so they remain available as resources for writers and researchers.
“I value librarians and people who are the guardians of information and truth,” said the donor, Molly Peacock ’69.
And, a “secret” poetry room was created in Glenn G. Bartle Library, reminiscent of a similar room she had discovered on campus when she was a student at Binghamton.
“I’m hoping that my legacy goes in the direction of something that’s individual and imaginative and not cookie cutter for Binghamton,” she added.
Learning to code — it’s not just for aspiring engineers anymore, thanks to your EXCELERATE support. The Binghamton Codes! Program gives undergraduate students the opportunity to learn coding skills even if they are not majoring in computer science.
In addition, Harpur College’s new digital and data studies minor provides interdisciplinary and hands-on immersion into digital literacy and data-inflected thinking.
The first pilot Binghamton Codes! course launched in spring 2020. Starting in fall 2024, students enrolled in the program have had access to the new Binghamton Codes! Center, located across from the College in the Woods Library.
Binghamton Codes! alumna, Gwyneht Lopez ’23, used the skills she learned to lead a summer coding program in her Washington Heights, N.Y., neighborhood. She also collaborated with the Parris Foundation on their STEMulating Saturdays program and stayed on as a tutor to continue providing support and encouragement.
The students she taught had never heard of Python, she said.
“They thought I was talking about a snake at first,” she quipped. “It was very rewarding to give them those tools, so that they can say one day, ‘Oh, I remember doing Python during the summer when I was 12, and I want to keep exploring that.’”



Student aid bridges financial gaps, opens doors and lifts barriers so students can achieve their dreams. More than 120 new scholarships were established during the EXCELERATE campaign, including emergency funding and Binghamton Fund for Opportunity Scholarships that provide crucial aid for students who need help right away or who may not qualify for other scholarship assistance.

EXCELERATE provided access in other ways, too. When classes moved online in spring 2020 amid the COVID-19 pandemic, many Binghamton students left campus to return home early for the rest of the semester, with some finding themselves with limited or no access to the resources and technology they previously had while on campus. Donors to the Binghamton Fund for Excellence came through with essential aid, enabling the Center for Learning and Teaching to provide 50 students in need with their own mobile WiFi hotspots, eliminating a barrier that impeded the students from continuing their education.



“ I chose to continue my education at Binghamton University because I was offered this scholarship.”
— Hanna Surdi ’19, PharmD ’23, inaugural recipient of the Schorr Family Foundation Pharmacy Scholarship

“ I felt as though all my hard work was seen and recognized,
which felt incredibly rewarding. This scholarship justified all the sacrifices that I had made during high school to prioritize my studies. I’m so immensely grateful.”
— Katie Kaufman ’25, recipient of the Nelson S. and Leona C. Fiske Decker College of Nursing Scholarship
“When I was accepted into the behavioral neuroscience graduate program, I was already beginning to worry about expenses and how I’d make it five-plus years, so receiving the Clark fellowship definitely appeased some of those anxieties.
I was overcome with an immense feeling of gratitude.”

— Ashley Bui, MS ’19, a
recipient of the Clifford D. Clark Diversity Fellowship for newly admitted graduate students
“ I am certain that if I had teaching obligations on top of my course and research load, I would not be as productive in my research.”
— Grascen Shidemantle,
PhD ’22, first recipient of the Grace Chin-Fa and Tsuming Wu Fellowship for the Sciences


Accepting the scholarship felt like “standing under a ray of sunshine beaming through the shadows.”
As a first-year student, Nusrat Islam ’24 received a Binghamton Fund emergency-relief scholarship. Before her very first semester, her parents had lost their jobs during the COVID-19 pandemic. She wondered if she’d have to give up her dream of becoming an oncologist. Thanks to you, the opportunity to be the first in her family to attend college in America hadn’t vanished.


The EXCELERATE campaign generated:
• Support for new and existing endowed positions that make Binghamton more competitive
• Seed grants for world-changing research, path-breaking discoveries and inspiring creative activities
• Resources to foster Interdisciplinary collaboration
• Support for programs that have global impact
Our faculty’s work permeates student labs and classrooms, multiplying their impact and yours as a supporter of faculty excellence.

Seed grants from The S. H. Ho Foundation Ltd. are advancing faculty research at the intersection of health sciences and technology:
• Jeffrey Mativetsky (physics) and Ahyeon Koh (biomedical engineering) are facilitating access to respiratory healthcare through wearable monitoring powered by artificial intelligence (AI).
• Pong-Yu Huang (mechanical engineering) and Paul Chiarot (mechanical engineering) are developing a non-invasive “smart shunt” that wirelessly monitors very small flow rates, so any problems in the treatment of hydrocephalus — the accumulation of excess fluid in the brain — can be detected and corrected.
• Wei Qiang (chemistry) and Minfei Su (chemistry) are examining structural polymorphisms and their Impact on Alzheimer’s disease pathology.
“Binghamton faculty are embarking on life-changing breakthroughs in technology, health sciences and more,” University President Harvey Stenger said. “This investment enhances Binghamton’s reputation for excellence and ensures faculty have crucial resources to develop research that makes a meaningful impact on the world.”


Improving the effectiveness of charity organizations, reducing medical errors and improving access to medical care are just some of the areas where Rory Eckardt has been applying his expertise and expanding his research as the first Dhillon Family Faculty Fellow, appointed in fall 2022.
The support provides an important tool to keep compensation packages competitive for productive faculty, which in turn, helps the School of Management continue producing impactful and cutting-edge research and high-quality classroom instruction, said Eckardt, associate professor of strategy.
“With the support, I have published eight papers (two of which are in the field’s top journals) over the last two years,” he said. “I have also helped to launch and lead a large multidisciplinary research project, which seeks to reimagine and substantially improve science related to workforce development and build a center of excellence for the School of Management.”


Established with an anonymous $1 million gift as part of the EXCELERATE campaign, the George Klir Professor in Systems Science is the first named professorship in the Thomas J. Watson College of Engineering and Applied Science, and it has an alumnus filling the role.
“It is my great honor and privilege to receive the support of the George Klir Endowment as I work to position the foundational field of systems science in a more vital role than ever for modern day science,” said Luis Rocha, PhD ’97, inaugural George Klir Professor in Systems Science since fall 2021.

“In my lab, we actively work to update Klir’s foundational research to solve current critical problems using modern terminology and concepts, thus engaging scientists from different fields in systems approaches,” he said. “It has resulted in many novel applications and discoveries, from genomics, brain science and epidemiology, to computational science and explainable artificial intelligence.”
Rocha has also been able to invite scientists from top international universities to Binghamton to collaborate and present their research. “These visits showcase both the current strength of the department with its impressive recent growth and the legacy and current relevance of systems science,” he said.
And, he’s teaching courses; training and mentoring graduate students, postdoctoral fellows and junior faculty; and helping shine the spotlight on Binghamton’s excellence. “The named professorship fortifies my scientific authority in the field and is often a topic of interest itself,” he said.
As inaugural Menner Family Endowed Faculty Fellow in Pharmacy, Tracy Brooks, associate professor and chair of the Department of Pharmaceutical Sciences, is developing cancer models that more accurately represent the human disease state, such as three-dimensional growths and co-culture with immune and other cancer environment-related cells. She uses these models in collaboration with medicinal chemists. Some of their more recent work focuses on lymphoma, pancreatic cancer, breast cancer and ovarian cancer with specific focus on factors that contribute to the more aggressive nature of the latter disease in Black women.
“Being the inaugural Menner Family Endowed Fellow has made a significant difference to my research and my career development,” Brooks said. “It has allowed me to purchase some equipment and resources that would not have been readily available without the support. We share our resources within the department and University as well, so this support has helped develop more than just my research program. Moreover, the support has allowed me to develop my career and expand my potential leadership and support the development of my students and staff through attending national scientific conferences and increasing the visibility of our work and of the students and staff.”


Faculty and students are poised to advance cancer treatment in the new Douglas Hsu Research Laboratory in the Biotechnology Building. The lab, dedicated in October 2023 as part of the EXCELERATE campaign, currently supports the cutting-edge cancer research of three PhD students and a master’s degree student.
One PhD student, Ming Lin, graduated in 2024. His groundbreaking work in building a pancreatic-tumor-on-chip for precision medicine has been published by Biomaterials, a top journal in biotechnology and bioengineering. This achievement is the result of a fruitful collaboration with colleagues at the Fox Chase Cancer Institute at Philadelphia.
“The Department of Biomedical Engineering will be able to purchase state-of-the-art equipment that will enable faculty and graduate students to pursue the most innovative research in this field and, more importantly, add to people’s health and well-being for generations to come,” University President Harvey Stenger said.


The EXCELERATE campaign produced an all-time high of annual support for the Binghamton Fund. Binghamton Fund gifts are essential because they provide flexible and immediate support for unexpected opportunities, emergency needs and key University priorities.
More than 25,000 EXCELERATE donors to the Binghamton Fund gave $16 million during the campaign, representing gifts from students, Bearcats of the Last Decade (BOLD) alumni, other alumni, parents, friends, faculty and staff.
Binghamton Fund gifts support each school and college and the University as a whole through the Binghamton Fund for Excellence. Donors also make Binghamton Fund Opportunity Scholarships possible — financial aid for students who may not be eligible for other scholarships.

“ I give back!”
Chloe Van Caeseele ’23 made her first gift to support Binghamton when she was a senior, in honor of her graduation year. The gift, to the Binghamton Fund for Excellence, connects the scholarship she had received, and resources she used at the Fleishman Center for Career and Professional Development, with her own budding philanthropy.


BINGHAMTON UNIVERSITY FOUNDATION BOARD OF DIRECTORS
OFFICERS
Stuart F. Koenig ’73, chair
Tyrone E. Muse, vice chair
Jeffrey S. Tucker ’84, treasurer
Anita J. Borkenstein ’86, secretary
DIRECTORS
Steven H. Bloom ’78, LHD ’10
Andrew Bonzani ’86
John M. Carrigg, MBA ’83
Cathleen M. Ellsworth ’86
Karen M. Feuer ’87
Judith Garczynski Fleishman ’90
Kenneth A. Goldblatt ’87
Abby R. Goldstein ’94
Mitchell S. Goldstein ’89
Donald E. Hall
Eric L. Hausler ’92
Keith L. Horn ’80
Alex Huppé ’69
Michael G. Kerner ’86
Charles M. Kim ’98
John C. Koch
Elizabeth M. Koffman
Dr. Bai O. Lee
Mitchell J. Lieberman ’80
Geraldine MacDonald ’68, MS ’73, LittD ’17
Carolyn M. Mancini
Kim Myers
Dr. Michael N. Needle ’81
Albert Nocciolino
James W. Orband ’81
Harvey G. Stenger
Michael D. Timmeny ’73
Cara R. Treidel ’16
Paul R. Turovsky ’73, LHD ’12
Howard D. Unger ’82, LHD ’19
Katherine E. Wanner ’89
Mark A. Zurack ’78, LHD ’03
CAMPAIGN COMMITTEE
Howard D. Unger ’82, LHD ’19, campaign chair
William E. Baldwin ’85
James B. Bankoski ’91
Anita J. Borkenstein ’86
Subhachandra Chandra, MS ’95
Subimal Chatterjee
Stephanie Courtney ’92
Robert L. Goldstein ’94
David Ho
Martha Ho, MA ’78
Karen A. Jones
Maggie Chan Jones ’96
Michael L. Joseph ’81
Roberta S. Joseph ’82
Dr. Karen E. Fuhrman Kerner ’86
Michael G. Kerner ’86
Anthony I. Kornheiser ’70, LittD ’17
Tyrone E. Muse
Elizabeth Bloomer Nesvold ’90
H. Peter Nesvold
Molly Peacock ’69
Ruben Santiago-Hudson ’78
Robert H. Swan, MBA ’85
Gary L. Truce
Jay H. Walder ’80
Susan A. Cummings-Walder ’81
Dr. Barry R. Witt ’80
Dr. Marjorie J. Strelzyn-Witt ’81